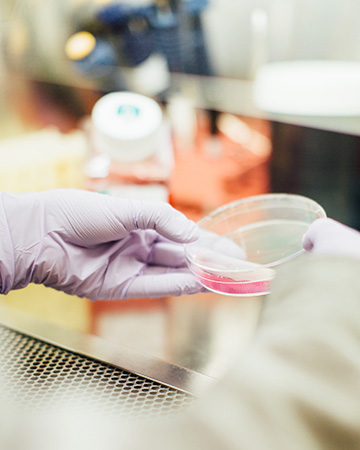
Image

서울여자대학교 산학협력단은 지식·인력 교류 인프라 확대를 위해
산학연 협력 활성화 방안으로 설립되었습니다.
서울여자대학교 산학협력단은 산학연 협력 활성화 방안으로 지신, 인력, 교류 인프라 확대를 위한 산학협력 전담조직으로 2004년 설립되었습니다.
서울여자대학교 산학협력단은 2017년 산학협력 중장기 발전계획을 수립하고 공감, 공익, 공유 산학협력 문화를 선도하는 PLUS형 인재양성을 비전으로 산학협력 중심 교육체질 개선, 지식기반 산학협력 인프라 구축, 지역연계 산학협력 추구를 3대 전략목표로 삼아 8개의 전략과제, 30개의 세부추진계획을 수행해왔습니다.
앞으로도 다양한 교내외사업을 통해 연구자의 역량을 강화하고 연구환경을 재고함으로써 연구결과의 양적, 질적 향상을 도모하고 산학연 협동을 통해 대학의 지식이 사회전반에 기여할 수 있도록 적극적으로 지원하고자 합니다.
산학협력의 발전을 위해 연구자분들의 많은 관심과 참여를 부탁드립니다.
서울여자대학교 산학협력단장한 원 식



